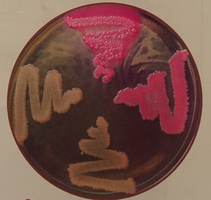
MacConkey agar plate with pink and colorless colonies

BackSelective and Differential Media in Microbiology: Principles and Applications
Study Guide - Smart Notes
Tailored notes based on your materials, expanded with key definitions, examples, and context.
Selective and Differential Media
Introduction to Selective and Differential Media
Selective and differential media are essential tools in microbiology for isolating and identifying microorganisms based on their physiological properties. These media contain specific ingredients that either inhibit the growth of certain microbes (selective) or allow visible distinction between different types of microbes (differential).
Selective Media: Contains chemical substances that inhibit the growth of some organisms while encouraging the growth of others.
Differential Media: Allows for the distinction between two or more different microbes by changing the medium or colony appearance based on microbial metabolism.

Key Definitions
Selective Medium: A medium that contains an inhibitor to prevent or slow the growth of undesired organisms.
Differential Medium: A medium formulated to show differences in the biochemical/physiological properties of organisms.
Coliform: Gram-negative rods that ferment glucose and share other traits; used as indicators of fecal contamination.
Enteric: Refers to gut bacteria, especially Enterobacteriaceae.
Coleiform: Enterobacteriaceae that produce acid and gas from lactose fermentation.
Noncoliform: Enterobacteriaceae that do not ferment lactose.

Types of Selective and Differential Media
Phenylethyl Alcohol Agar (PEA)
PEA is an undefined, selective medium that interferes with DNA synthesis in Gram-negative organisms, thus favoring the growth of Gram-positive bacteria.
Selective Agent: Phenylethyl alcohol
Purpose: Isolation of Gram-positive organisms
Mechanism: Inhibits DNA synthesis in Gram-negative bacteria

Eosin Methylene Blue (EMB) Agar
EMB agar is both selective and differential, used primarily for the isolation of fecal coliforms. It contains peptone, lactose, sucrose, eosin Y, and methylene blue.
Selective Agents: Eosin Y and methylene blue (inhibit Gram-positive bacteria)
Differential Agents: Lactose and sucrose (fermentation leads to acid production and color change)
Indicators: Eosin and methylene blue (form a dark purple complex with a green metallic sheen in strong fermenters)
Results:
Strong lactose fermenters (e.g., E. coli): Metallic green sheen
Slow fermenters (e.g., Enterobacter aerogenes): Brown-pink color
Non-fermenters: Colorless colonies

Mannitol Salt Agar (MSA)
MSA is a selective and differential medium used to differentiate Staphylococcus species based on their ability to ferment mannitol in a high-salt environment.
Selective Agent: 7.5% sodium chloride (inhibits most bacteria except staphylococci)
Differential Agent: Mannitol (fermentation produces acid)
Indicator: Phenol red (yellow below pH 6.8, red at pH 7.4–8.4, pink above 8.4)
Results:
S. aureus: Grows and ferments mannitol (yellow zone)
S. epidermidis: Grows but does not ferment mannitol (remains red/pink)
E. coli: Growth inhibited by high salt

MacConkey Agar (MAC)
MacConkey agar is a selective and differential medium used to isolate and differentiate members of the Enterobacteriaceae based on their ability to ferment lactose.
Selective Agents: Bile salts and crystal violet (inhibit Gram-positive bacteria)
Differential Agent: Lactose (fermentation produces acid)
Indicator: Neutral red (red below pH 6.8, colorless above)
Results:
Lactose fermenters (e.g., E. coli): Pink/red colonies
Non-fermenters (e.g., Salmonella, Proteus): Colorless colonies
Blood Agar
Blood agar is an enriched and differential medium used to detect hemolytic activity of bacteria, especially streptococci. It contains 5–10% sheep blood.
Enriched Medium: Supports growth of fastidious organisms
Differential Medium: Differentiates bacteria based on hemolysis (breakdown of red blood cells)
Types of Hemolysis:
Beta hemolysis: Complete destruction of RBCs (e.g., Streptococcus pyogenes)
Alpha hemolysis: Partial destruction of RBCs (e.g., Streptococcus pneumoniae)
Gamma hemolysis: No destruction of RBCs (e.g., Streptococcus faecalis)
Stabbing the Agar: Detects oxygen-sensitive hemolysins by providing a reduced-oxygen environment.
Summary Table: Key Selective and Differential Media
Medium | Selective Agent | Differential Agent | Indicator | Key Results |
|---|---|---|---|---|
PEA | Phenylethyl alcohol | None | None | Inhibits Gram-negative, allows Gram-positive |
EMB | Eosin Y, methylene blue | Lactose, sucrose | Eosin, methylene blue | Green sheen (strong fermenter), pink (slow), colorless (non) |
MSA | 7.5% NaCl | Mannitol | Phenol red | Yellow (fermenter), red/pink (non), no growth (sensitive) |
MAC | Bile salts, crystal violet | Lactose | Neutral red | Pink/red (fermenter), colorless (non) |
Blood Agar | None | Red blood cells | Hemolysis | Beta (clear), alpha (green), gamma (none) |
Applications and Importance
Selective and differential media are crucial for clinical diagnostics, environmental microbiology, and food safety testing.
They enable rapid identification and isolation of pathogens and indicator organisms from mixed samples.
Understanding the principles behind these media helps in interpreting laboratory results and troubleshooting culture-based assays.